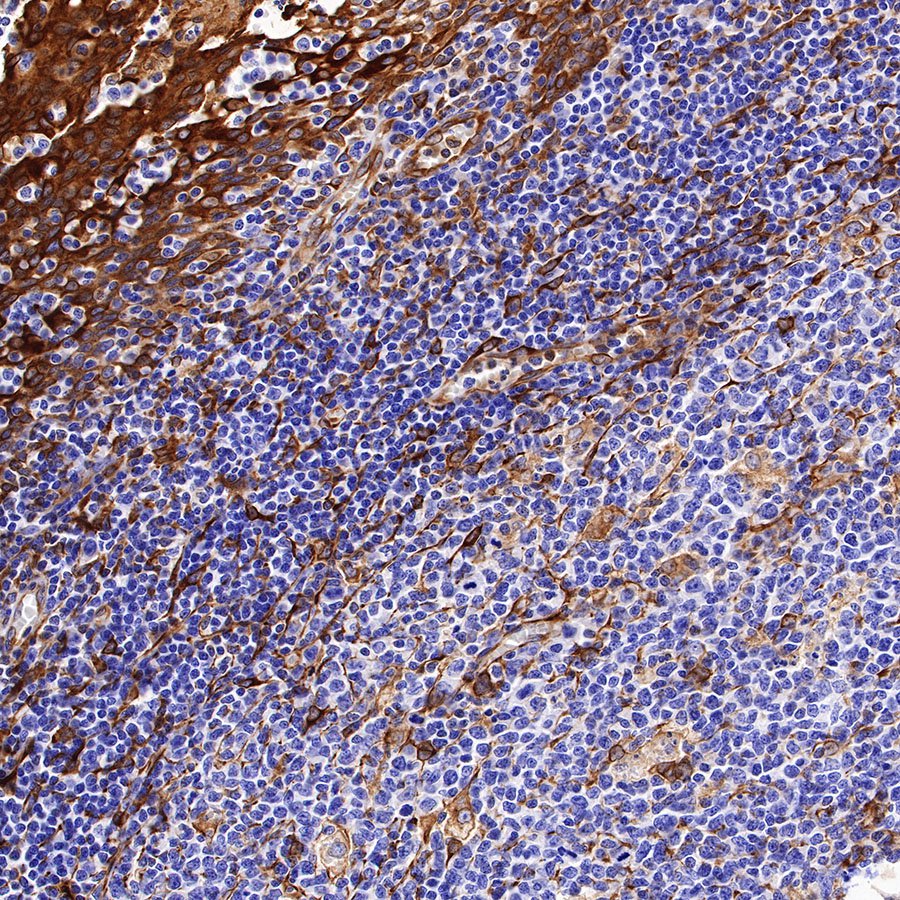

Product Details
Product Details
Product Specification
| Host | Rabbit |
| Antigen | STING |
| Synonyms | Hsting, ERIS, hMITA, Transmembrane protein 173 |
| Immunogen | N/A |
| Location | Cytoplasm, Cell membrane, Endoplasmic reticulum membrane, Mitochondrion outer membrane |
| Accession | Q86WV6 |
| Clone Number | SDT-R150 |
| Antibody Type | Recombinant mAb |
| Application | WB, IHC-P, IP |
| Reactivity | Hu |
| Purification | Protein A |
| Concentration | 0.5 mg/ml |
| Physical Appearance | Liquid |
| Storage Buffer | PBS, 40% Glycerol, 0.05% BSA, 0.03% Proclin 300 |
| Stability & Storage | 12 months from date of receipt / reconstitution, -20 °C as supplied |
Dilution
| application | dilution | species |
| WB | 1:1000 | null |
| IHC-P | 1:500 | null |
| IP | 1:50 | null |
Background
Mediator of IRF3 activation (MITA, also known as stimulator of interferon genes (STING) and endoplasmic reticulum interferon stimulator (ERIS)) is an ER-associated protein that senses cellular and bacterium-derived cyclic dinucleotide (CDN), leading to induction of type-I interferons (IFNs) and innate immune responses against viruses and bacteria [PMID: 36193584].
Picture
Picture
Western Blot

IP

STING Rabbit mAb at 1/50 dilution (1 µg) immunoprecipitating STING in 0.4 mg HL-60 whole cell lysate.
Western blot was performed on the immunoprecipitate using STING Rabbit mAb at 1/1000 dilution.
Secondary antibody (HRP) for IP was used at 1/400 dilution.
Lane 1: HL-60 whole cell lysate 20 µg (Input)
Lane 2: STING Rabbit mAb IP in HL-60 whole cell lysate
Lane 3: Rabbit monoclonal IgG IP in HL-60 whole cell lysate
Predicted MW: 42 kDa
Observed MW: 37 kDa
Immunohistochemistry